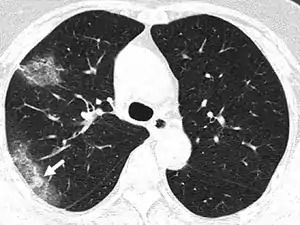

Silent hypoxia
Silent hypoxia (also happy hypoxia)[1][2] is hypoxia that does not coincide with shortness of breath.[3][4][5] It is known to be a complication of coronavirus disease 2019.[6][7] It is speculated that this condition is caused by SARS-CoV-2 affecting the blood flow of the lungs' airways, in addition to the blood vessels within the lungs, which must match in order to allow proper airflow, but not affecting them enough to cause shortness of breath.[8][9] It is also speculated that silent hypoxia may be caused by the formation of small blood clots within the lungs.[10][11][12] It has been shown that the breathing rates of patients with COVID-19 gradually increase, which in turn leads to silent hypoxia.[13] It has also been shown that COVID-19 patients experience lesser levels of shortness of breath after exercise than non-COVID-19 patients.[14] The condition is also known to be caused by walking pneumonia[15] and altitude sickness.[16][17][18]
| Silent hypoxia | |
|---|---|
| |
| Specialty | Critical care medicine, Infectious disease, pulmonology |
| Risk factors | COVID-19, altitude sickness |
Diagnosis
A tool used to diagnose silent hypoxia is the "six-minute walk test," (6MWT), wherein a patient walks at a normal pace for six minutes, in order to monitor their physiological response.[19] It has been proven that, after performing the 6MWT, COVID-19 patients were more likely to develop exercise-induced hypoxia without symptoms than non-COVID-19 patients who suffered from idiopathic pulmonary fibrosis.[20] The condition can also be first detected by using prehospital pulse oximetry.[21][22]
Prognosis
The prognosis for silent hypoxia is generally poor,[23][24] as oxygen levels in the blood can drop below 50 percent without being noticed.[25]
References
- Tobin MJ, Laghi F, Jubran A (August 2020). "Why COVID-19 Silent Hypoxemia Is Baffling to Physicians". American Journal of Respiratory and Critical Care Medicine. 202 (3): 356–360. doi:10.1164/rccm.202006-2157CP. PMC 7397783. PMID 32539537.
- LaMotte S (7 May 2020). "Silent hypoxia: Covid-19 patients who should be gasping for air but aren't". CNN.
- Pappas S (23 April 2020). "'Silent hypoxia' may be killing COVID-19 patients. But there's hope". Live Science.
- "Three reasons why COVID-19 can cause silent hypoxia". ScienceDaily. 19 November 2020.
- Emily H (3 June 2020). "Silent hypoxia and its role in COVID-19 detection". News Medical.
- Chandra A, Chakraborty U, Pal J, Karmakar P (September 2020). "Silent hypoxia: a frequently overlooked clinical entity in patients with COVID-19". BMJ Case Reports. 13 (9): e237207. doi:10.1136/bcr-2020-237207. PMC 7478026. PMID 32900744.
- Levitan R (20 April 2020). "The Infection That's Silently Killing Coronavirus Patients". The New York Times.
- "Silent Hypoxia Typically Not the First Symptom of COVID-19, Other Early Symptoms Should Be Monitored". American Lung Association. 15 May 2020.
- Gupta J (20 November 2020). "Three reasons why coronavirus can cause silent hypoxia". Hindustan Times.
- "COVID-19 complications: Silent hypoxia emerges as new killer in Kerala". The New Indian Express. 7 June 2020.
- "Study explains why Covid-19 can cause silent hypoxia". The Tribune. 30 November 2020.
- Srivastava A (23 May 2020). "Blood clots in the lung may be a major cause of COVID-19 deaths". The Hindu.
- Wei-Haas M (8 May 2020). "They don't struggle to breathe—but COVID-19 is starving them of oxygen". National Geographic.
- Fuglebjerg NJ, Jensen TO, Hoyer N, Ryrsø CK, Lindegaard B, Harboe ZB (October 2020). "Silent hypoxia in patients with SARS CoV-2 infection before hospital discharge". International Journal of Infectious Diseases. 99: 100–101. doi:10.1016/j.ijid.2020.07.014. PMC 7836996. PMID 32663601.
- Bowden O (12 May 2020). "What is 'silent hypoxia'? The coronavirus symptom patients don't know they have". Global News.
- Ottestad W. "COVID-19 patients with respiratory failure: what can we learn from aviation medicine?". British Journal of Anaesthesia. 125 (3).
- Gillespie C. "'Silent Hypoxia' Is Making Some Coronavirus Patients Critically Ill—Here's Why It's So Dangerous". Health.
- Blanchet D, Greene S. "Your Captain Speaking: Silent Hypoxia and COVID-19". EMS World.
- "Six-Minute Walk Test". American Lung Association.
- Fuglebjerg NJ, Jensen TO, Hoyer N, Ryrsø CK, Lindegaard B, Harboe ZB (October 2020). "Silent hypoxia in patients with SARS CoV-2 infection before hospital discharge". International Journal of Infectious Diseases. 99: 100–101. doi:10.1016/j.ijid.2020.07.014. PMID 32663601. S2CID 220530080.
- Luks AM, Swenson ER (September 2020). "Pulse Oximetry for Monitoring Patients with COVID-19 at Home. Potential Pitfalls and Practical Guidance". Annals of the American Thoracic Society. 17 (9): 1040–1046. doi:10.1513/AnnalsATS.202005-418FR. PMC 7462317. PMID 32521167.
- Torjesen I (27 October 2020). "Covid-19: Patients to use pulse oximetry at home to spot deterioration". The BMJ: m4151. doi:10.1136/bmj.m4151. S2CID 225078120.
- Brouqui P, Amrane S, Million M, Cortaredona S, Parola P, Lagier JC, Raoult D (January 2021). "Asymptomatic hypoxia in COVID-19 is associated with poor outcome". International Journal of Infectious Diseases. 102: 233–238. doi:10.1016/j.ijid.2020.10.067. PMID 33130200.
- Lari A, Alherz M, Nouri A, Botras L, Taqi S (December 2020). "Caution against precaution: A case report on silent hypoxia in COVID-19". Annals of Medicine and Surgery. 60: 301–303. doi:10.1016/j.amsu.2020.11.007. PMID 33169089.
- Teo J (June 2020). "Early Detection of Silent Hypoxia in Covid-19 Pneumonia Using Smartphone Pulse Oximetry". Journal of Medical Systems. 44 (8): 134. doi:10.1007/s10916-020-01587-6. PMC 7305055. PMID 32562006.